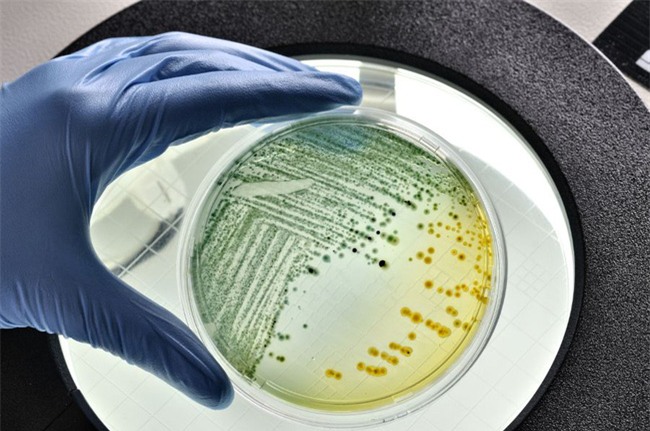
Những thứ đáng sợ này trong vòi hoa sen có thể khiến bạn mang bệnh - Ảnh 1.

Vòi hoa sen ẩm ướt và ấm áp nên bất cứ vi khuẩn nào sinh sống bên trong đều được bổ sung chất dinh dưỡng sau mỗi lần chúng ta tắm.
Nếu bạn phát hiện ra nấm mốc
phát triển trên cửa hoặc vật dụng nào đó trong nhà tắm, chắc chắn bạn
sẽ làm sạch nó ngay lập tức. Nhưng có bao giờ bạn băn khoăn về chuyện
"liệu vi khuẩn có ở vòi hoa sen
hay không"? Nếu câu trả lời là "Không" thì tức là bạn giống với rất
nhiều người - những người hiếm khi quan tâm đến chuyện vệ sinh vòi hoa
sen dù vẫn tắm hàng ngày.
Vòi hoa sen là một trong những nơi tuyệt vời cho các loại vi khuẩn, nấm mốc sinh sôi.
Theo Matthew Gebert, kỹ thuật viên nghiên cứu tại Phòng thí nghiệm Fierer thuộc Viện nghiên cứu Hợp tác Khoa học Môi trường thuộc Đại học Colorado ở Boulder: "Ở trong nhà, vòi hoa sen là một trong những nơi tuyệt vời cho các loại vi khuẩn, nấm mốc sinh sôi". Matthew Gebert còn là thành viên tham gia Dự án Showerhead Microbiome Project - một nghiên cứu về những gì đang sống bên trong vòi hoa sen được thực hiện trên khắp đất nước. Ông cũng tin rằng, vòi hoa sen ẩm ướt và ấm áp nên bất cứ vi khuẩn nào sinh sống bên trong đều được bổ sung chất dinh dưỡng sau mỗi lần chúng ta tắm.
Aaron E. Glatt, MD, một chủ nhiệm khoa tại Bệnh viện South Nassau Community ở Oceanside, New York, chuyên gia về bệnh truyền nhiễm và phát ngôn viên của Hiệp hội Bệnh truyền nhiễm Hoa Kỳ, cho rằng, hầu hết vi khuẩn trong vòi hoa sen không có hại và không cần lo lắng quá.

Không phải lúc nào vi khuẩn trong vòi hoa sen cũng gây hại...
Cùng quan điểm này, Gebert nói thêm: "Rất nhiều loại vi khuẩn có lợi và có tác dụng giúp tăng cường hệ thống miễn dịch khỏe mạnh. Chúng ta tiếp xúc với vi khuẩn hàng ngày - trong bụi, trong không khí, trong thực phẩm, thông qua tiếp xúc với người khác, tiếp xúc với vật nuôi... và rất ít trong số đó thực sự làm cho chúng ta bị bệnh. Vì vậy, dù có vi khuẩn sống trong vòi hoa sen cũng không có nghĩa là bạn đang có nguy cơ cao mắc bệnh phổi hoặc da. Điều này cũng không có nghĩa là bạn cần vứt bỏ vòi hoa sen đi. Mắc bệnh là trường hợp xấu chúng ta gặp và cũng phải hết sức cẩn trọng".
Gebert cũng nói: "Các vi khuẩn bên trong vòi hoa sen rất hợp với nhau và tạo ra các "cộng đồng" bên trong đó và cũng có thể làm cho bạn bị ốm bất cứ khi nào có cơ hội".
Vi khuẩn không lây nhiễm Mycobacteria (NTT) là một trong những loại vi khuẩn được tìm thấy trong vòi hoa sen. Loại vi khuẩn này sản sinh tự nhiên trong nước và đất. Mặc dù nhiều loài của NTM (trên 150 loài) hoàn toàn vô hại nhưng cũng có những loại khác khác lại có thể gây nhiễm trùng phổi nặng, đặc biệt ở những người có hệ miễn dịch suy yếu.

... nhưng chúng ta vẫn phải cẩn trọng.
Một loại vi khuẩn khác trong vòi hoa sen là Legionella pneumophila. Legionnaire có thể gây ra bệnh viêm phổi bằng cách xâm nhập vào hệ thống hô hấp của bạn dù là với lượng rất nhỏ.
Vì vậy, thay vì phó mặc cho số phận và hi vọng vào sự "hiền lành" của các vi khuẩn, chúng ta nên bảo vệ mình theo một vài cách đơn giản nhất có thể làm được như:
- Chuyển sang vòi hoa sen bằng kim loại: Các nhà nghiên cứu cho thấy rằng vi khuẩn có nhiều khả năng tích lũy trong đồ đạc bằng nhựa, vòi hoa sen bằng nhựa cũng vậy.
- Làm sạch vòi hoa sen thường xuyên: Vệ sinh vòi hoa sen không phải là việc quá phức tạp. Bác sĩ Glatt khuyên bạn chỉ cần thỉnh thoảng làm sạch vồi hoa sen bằng cách dùng bàn chải đánh răng cũ để cọ rửa, làm sạch bộ lọc... Hoặc bạn có thể dùng dấm để khử trùng bằng cách ngâm vòi hoa sen trong dấm trong khoẳng 1 giờ, sau đó làm sạch lại.
"Hãy nhớ rằng: Không có sản phẩm hoặc kỹ thuật nào có thể loại bỏ hoàn toàn vi khuẩn khỏi vòi tắm của bạn. Sau một vài ngày, những con vật vô cùng nhỏ bé này sẽ trở lại nhưng việc vệ sinh vẫn là cần thiết", Glatt nói.

- Thận trọng khi dùng vòi hoa sen công cộng: "Nếu thấy vòi hoa sen công cộng không sạch sẽ, nhất là khi nhìn thấy dính cả máu hoặc phân thì nhất định không được dùng. Nguyên nhân là vì như vậy bạn sẽ có nguy cơ nhiễm vi khuẩn cao hơn, đặc biệt nếu bạn có vết thương hở trên người, vi khuẩn càng dễ xâm nhập vào cơ thể", bác sĩ Glatt nói: "
Lưu ý: Nếu hệ miễn dịch của bạn đang kém hoặc bị tổn thương, hãy cân nhắc việc tắm vòi hoa sen, thay vào đó tắm theo cách khác. Điều này sẽ làm giảm nguy cơ nhiễm vi khuẩn nguy hiểm vì vi khuẩn sẽ không có cơ hội chui vào qua mũi hoặc miệng của bạn.
Theo Trí thức trẻ